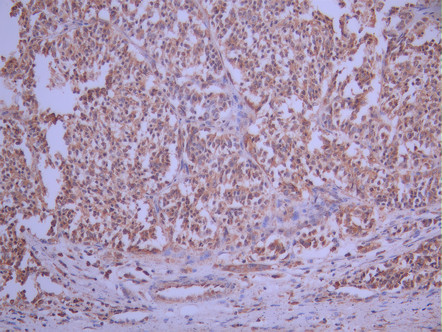

GDF11 Recombinant Monoclonal Antibody
-
中文名稱:GDF11 Recombinant Monoclonal Antibody
-
貨號:CSB-RA916692A0HU
-
規格:¥1320
-
圖片:
-
Western Blot
, Positive WB detected in:HepG2 whole cell lysate(30μg)
All lanes: BMP11 antibody at 1:1000
Secondary
Goat polyclonal to rabbit IgG at 1/40000 dilution
Predicted band size: 45 kDa
Observed band size: 45 kDa
Exposure time:120s -
IHC image of CSB-RA916692A0HU diluted at 1:100 and staining in paraffin-embedded human brain tissue performed on a Leica BondTM system. After dewaxing and hydration, antigen retrieval was mediated by high pressure in a citrate buffer (pH 6.0). Section was blocked with 10% normal goat serum 30min at RT. Then primary antibody (1% BSA) was incubated at 4°C overnight. The primary is detected by a Goat anti-rabbit polymer IgG labeled by HRP and visualized using 0.05% DAB.
-
IHC image of CSB-RA916692A0HU diluted at 1:100 and staining in paraffin-embedded human liver cancer performed on a Leica BondTM system. After dewaxing and hydration, antigen retrieval was mediated by high pressure in a citrate buffer (pH 6.0). Section was blocked with 10% normal goat serum 30min at RT. Then primary antibody (1% BSA) was incubated at 4°C overnight. The primary is detected by a Goat anti-rabbit polymer IgG labeled by HRP and visualized using 0.05% DAB.
-
Overlay Peak curve showing A431 cells stained with CSB-RA916692A0HU (red line) at 1:100. The cells were fixed in 4% formaldehyde and permeated by 0.2% TritonX-100 for 10min. Then 10% normal goat serum to block non-specific protein-protein interactions followed by the antibody (1ug/1*106cells) for 45min at 4℃. The secondary antibody used was FITC-conjugated goat anti-rabbit IgG (H+L) at 1/200 dilution for 35min at 4℃.Control antibody (green line) was Rabbit IgG (1ug/1*106cells) used under the same conditions. Acquisition of >10, 000 events was performed.
-
-
其他:
產品詳情
-
Uniprot No.:
-
基因名:
-
別名:BMP 11 antibody; BMP-11 antibody; BMP11 antibody; Bone morphogenetic protein 11 antibody; GDF 11 antibody; GDF-11 antibody; Gdf11 antibody; GDF11_HUMAN antibody; Growth differentiation factor 11 antibody; Growth/differentiation factor 11 antibody
-
反應種屬:Human
-
免疫原:A synthesized peptide from human GDF11 protein
-
免疫原種屬:Homo sapiens (Human)
-
標記方式:Non-conjugated
-
克隆類型:Monoclonal
-
抗體亞型:Rabbit IgG
-
純化方式:Affinity-chromatography
-
克隆號:10B4
-
濃度:It differs from different batches. Please contact us to confirm it.
-
保存緩沖液:Rabbit IgG in 10mM phosphate buffered saline , pH 7.4, 150mM sodium chloride, 0.05% BSA, 0.02% sodium azide and 50% glycerol.
-
產品提供形式:Liquid
-
應用范圍:ELISA, WB, IHC, FC
-
推薦稀釋比:
Application Recommended Dilution WB 1:500-1:5000 IHC 1:50-1:200 FC 1:50-1:200 -
Protocols:
-
儲存條件:Upon receipt, store at -20°C or -80°C. Avoid repeated freeze.
-
貨期:Basically, we can dispatch the products out in 1-3 working days after receiving your orders. Delivery time maybe differs from different purchasing way or location, please kindly consult your local distributors for specific delivery time.
-
用途:For Research Use Only. Not for use in diagnostic or therapeutic procedures.
相關產品
靶點詳情
-
功能:Secreted signal that acts globally to regulate anterior/posterior axial patterning during development. May play critical roles in patterning both mesodermal and neural tissues. It is required for proper vertebral patterning and orofacial development. Signals through activin receptors type-2, ACVR2A and ACVR2B, and activin receptors type-1, ACVR1B, ACVR1C and TGFBR1 leading to the phosphorylation of SMAD2 and SMAD3.
-
基因功能參考文獻:
- The serum content of GDF11 was much less in esophageal cancer patients than in the control group. Esophageal GDF II in cancer patients was correlated with cancer differentiation: the higher the degree of differentiation, the higher the content of GDF11. PMID: 30213293
- Physical inactivity was significantly related to the decreased GDF11 levels in COPD. PMID: 29731621
- GDF11 expression was decreased in COPD patients' serum and cells when compared with that of healthy people. PMID: 29680737
- GDF11 may be a relevant myostatin-interacting peptide to successful aging in humans PMID: 28701523
- The Growth Differentiation Factor 11 (GDF11) and Myostatin (MSTN) in tissue specific aging. PMID: 28472635
- Tumor-suppressor inactivation of GDF11 occurs by precursor sequestration in triple-negative breast cancer PMID: 29161592
- These studies identify distinctive structural features of GDF11 that enhance its potency, relative to GDF8; however, the biological consequences of these differences remain to be determined. PMID: 28257634
- In elderly Chinese women, osteoporosis risk was significantly increased with increases in GDF11 serum levels. PMID: 27557752
- A Prodomain Fragment from the Proteolytic Activation of Growth Differentiation Factor 11 Remains Associated with the Mature Growth Factor and Keeps It Soluble PMID: 28715204
- MSTN, but not GDF11, declines in healthy men throughout aging. PMID: 27304512
- GDF11 is highly concentrated in human platelets. PMID: 27509407
- The crystal structure of GDF11 was determined to a resolution of 1.50 A. PMID: 26919518
- GDF11 is essential for mammalian development and has been suggested to regulate aging of multiple tissues. It functions in the heart, skeletal muscle, and brain. Review. PMID: 27034275
- GDF11 inhibits rather than helps muscle regeneration. PMID: 26001423
- Show that there is no age-related cardiac hypertrophy in disease-free 24-month-old C57BL/6 mice and that restoring GDF11 in old mice has no effect on cardiac structure or function. PMID: 26383970
- in vitro sprout formation was increased as well by GDF11 treatment PMID: 26026854
- Suggest GDF11 functions as encephalic regionalizing factor in neural differentiated mouse embryonic stem cells. PMID: 25352416
- GDF11 is a critical rheostat for bone turnover and a key integrator of bone homeostasis. PMID: 25534870
- These data demonstrate GDF11 to be a master regulator of neural stem cell transcription that can suppress cell proliferation and migration by regulating the expression of numerous genes involved in both these processes PMID: 24244313
- Expression of GDF11, a cytokine which blocks terminal erythroid maturation, was increased in erthyroblasts of thalassemic patients. PMID: 24658077
- Quantitative real-time reverse transcription-PCR in colorectal cancer specimens obtained from 130 patients showed that GDF11 mRNA expression in cancer tissue was significantly higher than in normal tissue PMID: 17912435
- Members of the transforming growth factor beta (TGFbeta) superfamily, bone morphogenetic protein 2 (BMP2), and growth and differentiation factor 11 (GDF11), can signal cultured RGCs to form dendrites. PMID: 17997109
- We propose that Pcsk5, at least in part via GDF11, coordinately regulates caudal Hox paralogs, to control anteroposterior patterning, nephrogenesis, skeletal, and anorectal development. PMID: 18519639
- Differential antagonism of activin, myostatin and growth and differentiation factor 11 by wild-type and mutant follistatin. PMID: 18535106
- Both WFIKKN1 and WFIKKN2 have high affinity for growth and differentiation factors 8 and 11. PMID: 18596030
- Myostatin or 20 ng/mL BMP-11 maintain the colony and cellular morphology of undifferentiated hESC, maintain POU5f1, NANOG, TRA-1-60, and SSEA4 expression, and display increased SMAD2/3 phosphorylation PMID: 19751112
顯示更多
收起更多
-
亞細胞定位:Secreted.
-
蛋白家族:TGF-beta family
-
組織特異性:In the embryo, strong expression is seen in the palatal epithelia, including the medial edge epithelial and midline epithelial seam of the palatal shelves. Less pronounced expression is also seen throughout the palatal shelf and tongue mesenchyme.
-
數據庫鏈接:
Most popular with customers
-
-
YWHAB Recombinant Monoclonal Antibody
Applications: ELISA, WB, IHC, IF, FC
Species Reactivity: Human, Mouse, Rat
-
Phospho-YAP1 (S127) Recombinant Monoclonal Antibody
Applications: ELISA, WB, IHC
Species Reactivity: Human
-
-
-
-
-